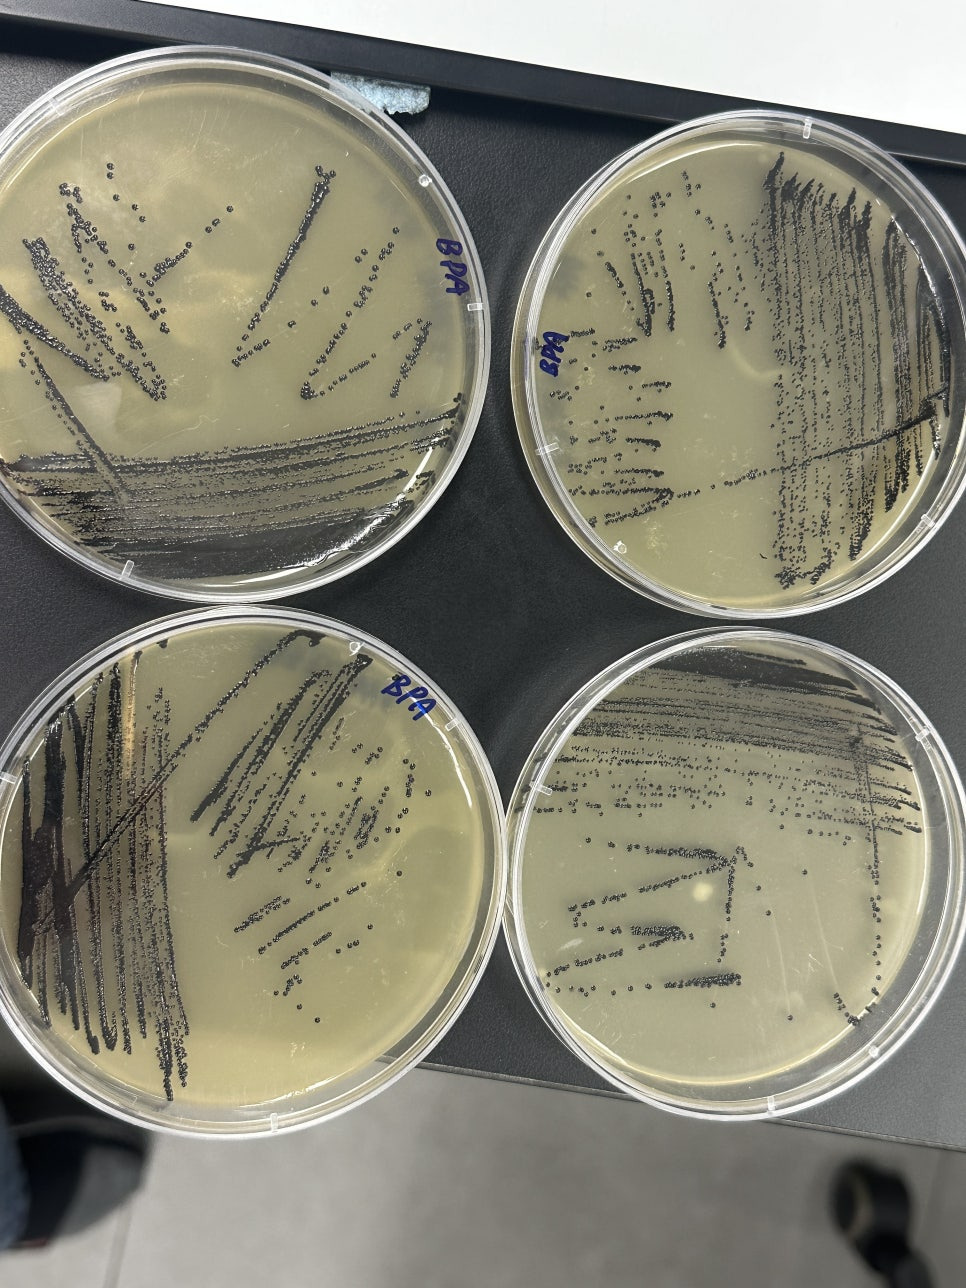

안녕하세요,
한국식품정보원 대전교육장입니다.

날이 점점 따뜻해지면서,
식중독 우려도 커지고 있어요.

AI 활용
이런 식중독 원인균 관리는
식품 안전 관리에서 필수적이죠.
철저한 관리를 위해서
미생물 실험, 특히 병원성미생물 실험은 정말 중요한 업무에요.
그래서 오늘은 이러한 미생물 실험 역량을 키워줄 교육 후기를 들려드리려 해요.

'병원성미생물3종(실습)'의 교육 후기입니다!
이번 게시물에서 소개되는 교육과정은 3/4-6(수-금)에 진행된 교육입니다.
교육 내용보다는, 진행된 모습들을 보여드릴 예정이에요.
자세한 교육 내용이 궁금하시다면, 아래 링크를 클릭해보세요!
🔽🔽🔽
[KFI] 🧫병원성 미생물 3종(황색포도상구균, 살모넬라, 리스테리아) 실습 교육 후기 :: 대전교육장
안녕하세요! 한국식품정보원입니다 ;) 오늘은 대전교육장에서 진행됐던 병원성 미생물 3종 실습 교육 후기...
blog.naver.com

오전에는 이론강의가 진행됩니다.
병원성 미생물의 일반특성과 검사 방법, 배지 제조등에 대해 미생물 전문 강사님이
자세하게 알려주세요.
교육에 진행하는 균주뿐만 아니라
주요 식중독균에 대해서도 강사님께서 친절히 알려주시니
이해가 쏙쏙! 잘 되실거에요.

이론 강의를 바탕으로, 배지 제조 실습을 진행해봅니다.
균에 따라 적용되는 배지의 종류가 다르기 때문에
여러 종류의 배지를 제조해보는 시간을 가져보아요.

배지를 제조하는데에도 강사님이 친절히 알려주신답니다.
제조하고 분주하여 균주를 접종할 배지를 완성합니다.
이후 균주들을 접종하면
이렇게 균이 자란 것을 확인할 수 있어요.
사진 속 균주는 황색포도상구균으로, BPA배지에 접종한 결과에요

확인시험을 위한
API kit에도 균주를 접종해봅니다.

그람염색을 진행하여, 균주의 특징을 확인해봅니다.

이후 현미경으로 직접 확인을 해봅니다!
여기까지 미생물 교육의 이모저모를 살펴보았어요,
이제 교육생의 후기를 살펴볼까요?

반려동물 기업에서 오신 교육생 A님은 업무를 위해
참여를 해주셨는데요,
기초적인 사용법뿐만 아니라, 식품안전기사에서
어려웠던 부분까지 상세히 배울 수 있어 좋았다고
응답해주셨어요.
특히 "8종의 주료 병원성 미생물 중에 정량법이
있는 3종에 대해 설명해주셔서,
현업에서 외부분석기관에 의뢰시 원활하게 업무를
수행할 수 있을 것 같다.
원료의 미생물 분석에 활용할 수 있을 것 같고,
체계적으로 실험방법을 익히고 싶은 분들께
매우 도움이 될 것 같다"고
후기를 남겨주셨어요.
교재에 이론 및 실험법이 상세히 수록되어 있어,
교육 후 필요할때마다 참고서처럼
활용 할 수 있을 것 같아 좋았다고 말씀해주셨어요.
열정적으로 참여해주시고, 또 정성 가득한 후기를 남겨주신 교육생 A님께 감사드리며,
앞으로의 업무와 또 자격증 취득에도 큰 도움이 되시길 바랍니다.

한국식품정보원에서는 다양한 미생물 교육을 운영하고 있어요.
내 업무나 상황에 알맞은 교육을 선택해서 들으면 더 효과적이겠죠?
아래 이미지를 참고하셔서, 나에게 맞는 교육을 확인해보세요!

앞으로 다양한 교육 후기로 여러분들을 찾아뵐게요.
감사합니다~
★다음카페 '식품안전의 모든것' http://cafe.daum.net/foodi114
★다음카페 '식품기술사가 되는길' http://cafe.daum.net/foodpe1
★유튜브 https://www.youtube.com/@k-foodi




대전광역시 유성구 반석로 14 7-9층
서울특별시 송파구 법원로 128 A동 1006호